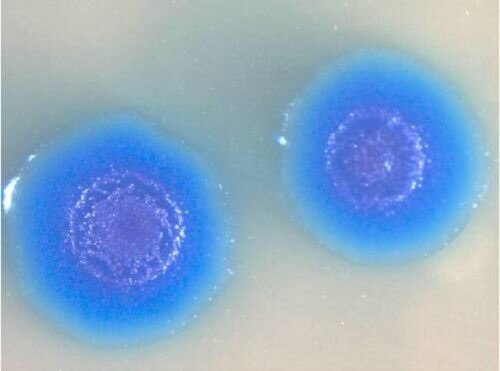
Колонии <em>Mycoplasma labora</em><em>torium</em>

В настоящий момент времени квантовая механика как теоретическая основа физики микромира добилась широкой практической реализации комплекса закономерностей, описывающих и определяющих явления микромира. Будучи в своём основании контринтуитивной человеческому восприятию мира, квантовая механика является способом понимания явлений микромира и выделения общих правил, в соответствии с которыми происходит становление теорий обобщающего плана, описывающих Вселенную как единое целое в совокупности взаимодействий — гравитационного, электромагнитного, сильного, слабого — имеющих частицы-переносчики взаимодействий, которые позволяли бы их детектировать. Существование самих частиц происходит в форме превращений — изменений состояния частиц, а квантовая механика представляет собой теорию подобных превращений. Каждое состояние частицы описывается волновой функцией, определяющей собственно эволюцию квантовой системы и коллапсирующей при неконтролируемом взаимодействии системы с макроскопической средой [2].
Выводы квантовой теории позволяют использовать лишь математический аппарат квантовой механики в качестве описания явлений микромира и практического приложения теоретического опыта. При этом теоретическая основа квантовой механики способна найти отражение во многих отраслях науки, в частности, в современной биологии как в комплексной науке о жизни.
Возможность использования квантовой теории в биологии опосредуется главным образом существующей проблемой отсутствия понимания ключевого аспекта уникальности природы жизни, её основания и фактического начала, определяющего комплекс проявлений существования жизни как феномена в мире. Доказательство существования одной из ключевых ролей квантовых явлений и превращений в биохимических процессах свидетельствует о необходимости осознания комплексного характера влияния процессов квантового мира на биологические системы.
Многочисленные исследования, проанализированные Дж. Аль-Халили и Дж. Макфадденом, свидетельствуют о роли квантовых превращений в таких биохимических процессах, как движение электронов по дыхательным цепям, процесс фотосинтеза и т.п., и даже в тех процессах, которые определяют ключевой уникальный феномен живого — формирование сознания.
Комплексная реализация биохимических процессов реализуется при помощи элементарных частиц — электронов, протонов — которые, характеризуясь квантовой когерентностью, реализуют всю совокупность явлений квантового мира, определяя подобным образом формирование высокой упорядоченности и многочисленных преимуществ протекания подобных процессов в живом веществе. Непременно должная быть достигнутой декогеренция как результат взаимодействия элементов микромира с макрометрическими объектами (белками, биологически активными веществами организма человека и др. факторами макромира, создающими так называемый «молекулярный шум») преодолевается в неживой природе использованием, к примеру, низких температур, близких к абсолютному нулю, в то время как в живой природе физические характеристики «молекулярного шума» соответствуют оптимальным условиям осуществления квантовомеханических процессов и сохранения квантовой когерентности. Следовательно, необходимо отметить ключевое значение осуществления процессов квантового мира как элементов важнейших химических процессов поддержания жизни, протекание которых оптимальным образом в оптимальных условиях становится генетически опосредованным необходимым условием возможности существования жизни.
Перспективы развития квантовой биологии весьма интересны. Наука, определяющая осуществление процессов живого в контексте принципов и закономерностей квантовой механики, призвана в первую очередь объяснить ключевую основу, наиболее важный аспект, определяющий жизнь в сущностном плане. Дж. Аль-Халили и Дж. Макфадден полагают основой механизма жизни «квантовую искру жизни». Таким образом, авторы определяют основой жизни сопричастность квантовому миру, формирование упорядоченности путём осуществления процессов, раскрывающих особенности квантовых явлений. Авторы указывают на гипотетический характер подобной теории, не могущей найти комплексной практической реализации в современных условиях развития науки, отмечая при этом возможность разрушения мистических и метафизических представлений о жизни в результате разработки подобной стройной научной теории, комплексно и всесторонне объясняющей природу движущей силы жизни [1].
Другим направлением развития квантовой биологии становится весьма привлекательная возможность искусственного создания жизни полностью из неживых компонентов. На данный момент наиболее существенного прогресса наука сумела добиться при формировании искусственного генома Mycoplasma laboratorium — организма бактерии, полученного наиболее синтетическим из возможных способов, продиктованных наукой на данный момент (для синтеза были использованы генетический материал и клеточные структуры природной бактерии Mycoplasma genitalium) [3].
Квантовая биология, в свою очередь, полагает возможным создание полностью искусственно жизни, лишённой какого-либо природного органического основания. Подобные мероприятия позволят более детально и основательно понимать характер и направленность, важность и значение отдельных аспектов физического воплощения жизни, что способно сделать возможным проведение грамотного регулирования процессов живого, контролируя возможные «сбои» и случайные флуктуации, нарушения основных механизмов протекания процессов.
На сегодняшний день квантовая биология как наука находится в состоянии формирования теоретической базы. При этом данная наука обладает большим практическим потенциалом и способна привести человечество к более точному пониманию жизни как биологического феномена. Исследования в данной области продолжаются, распространяясь на более мелкие уровни организации живого как структурные единицы комплекса — живого организма.